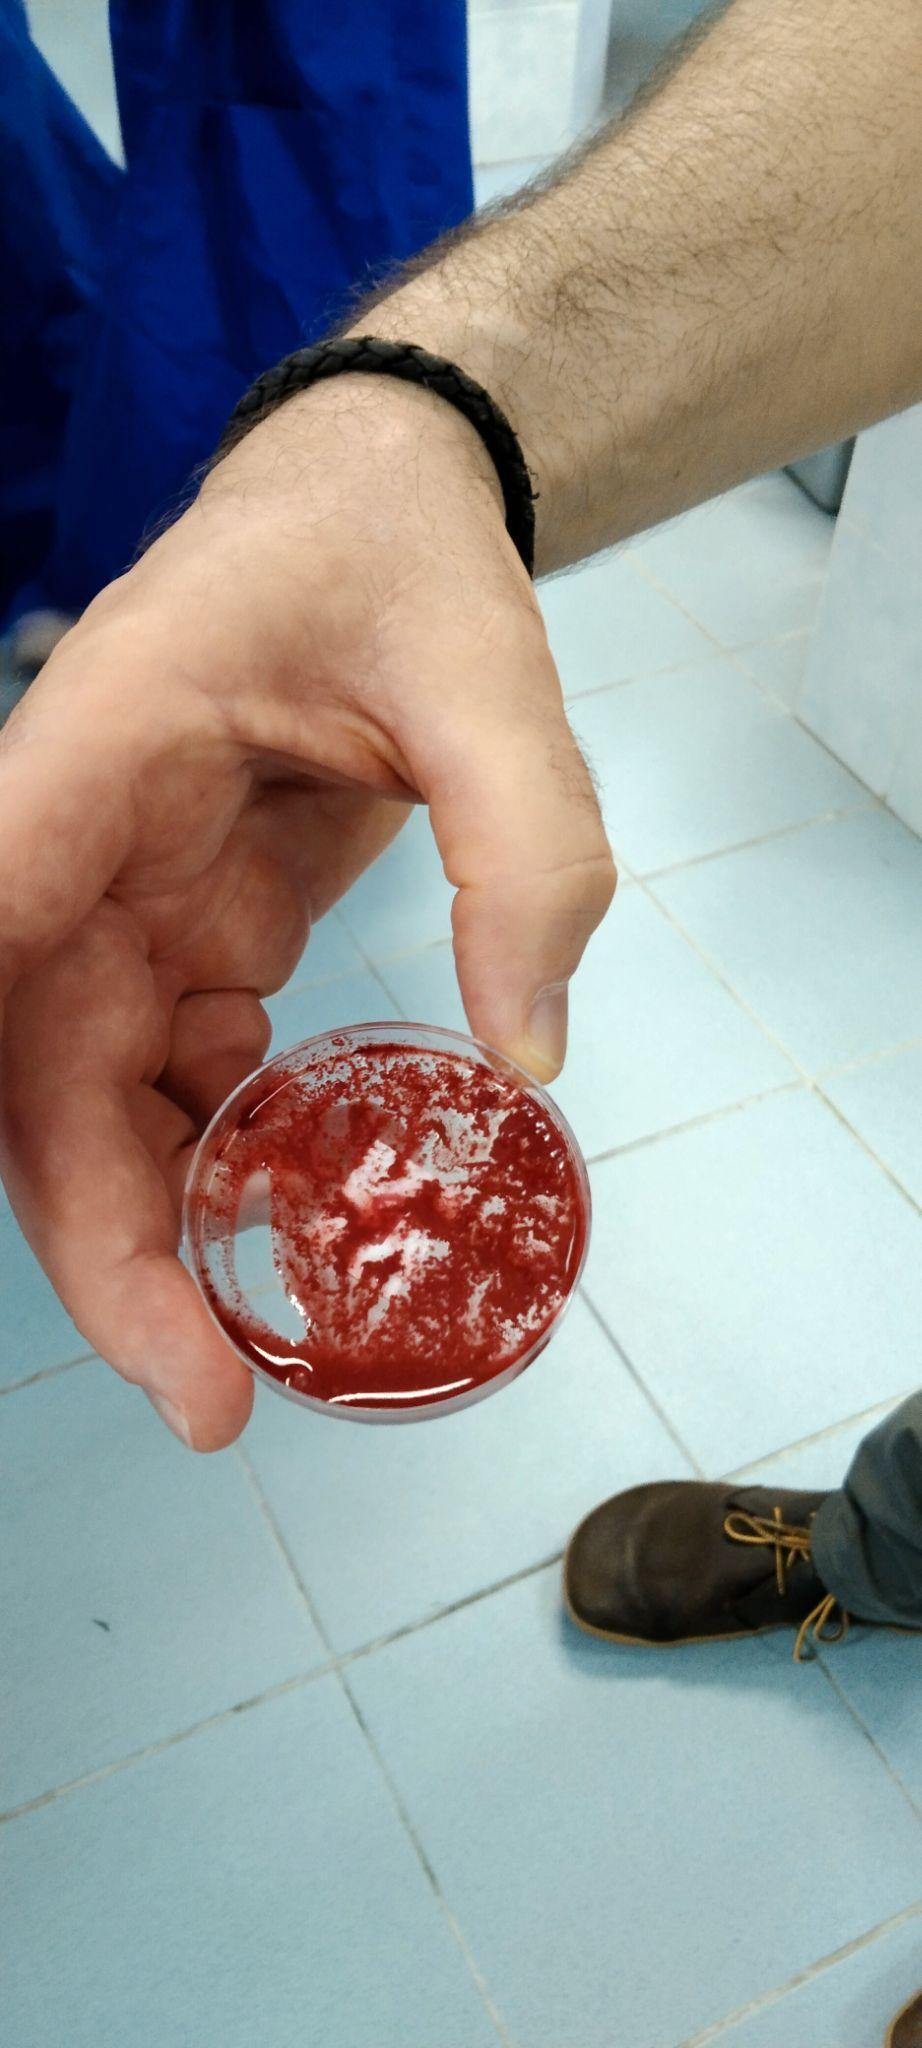

Panaga School Biweekly










We have started Term 2 off with Science Week in Teraja and Melilas, with lots of new and interesting learning to promote this important subject area. Look out for this and other learning celebrations presented in this week’s edition of Panaga SchoolBiweekly(PSB).
Together Improving Learning is our vision and purpose at Panaga School. Teacher training and learning reviews contribute to our great learning and we are pleasedtoprovideourcommunitywithdevelopmentsintheseareas.
The teaching of English requires a consistent and scaffolded approach across a learning organisation, to build student capabilities. Panaga School teachers will participate in English Writing Professional Development throughout Term 2, in evening online training sessions with Maria Richards, who is an expert in this field. Maria has previously visited Panaga School twice. During this time she has been instrumental in the development of English teaching and learning at Panaga School.WearepleasedtobeworkingwithMariaagain.
Panaga School participates in accreditation and learning review processes to help usreflectonourpracticeandbuildimprovementagendas.Alearningreviewwillbe taking place in February 2023. This will involve 2 independent education consultants visiting Panaga School for a week. During our learning review, consultants will visit every class, meet with all school leaders, view school plans, policies and procedures, speak with parents, students and other relevant key stakeholders. Our parent community will be provided with an overview of this report.
Each year our teachers offer professional development to local schools and teachers. On Friday 27th January we have 30 teachers from Seri Mulia Sarjana School visiting Rampayoh site, to develop their knowledge, skills and understanding of the International Primary Curriculum. They will have training sessionswithourstaffandtheywillalsohavetheopportunitytovisitclassroomsto lookatlearningenvironments.Theywillbewithusfrom7.30am-11.30am.
Wishing everybody a safe and lovely long weekend. We especially wish our Chinese Community celebrating a Happy Chinese New Year. We look forward to a whole school Chinese New Year assembly next week.







From 5pm arrival, food vendors will be selling food and drinks with cash sales only. 5.20pm Chinese lion dance begins
5.30pm Program Begins and will include a variety of cultural dance and drama performances.
Feel free to dress in cultural attire, bring a blanket/picnic/picnic hamper if you wish. Please bring a water bottle. This event is for Panaga School Community members only.
Parents are welcome to attend throughout the morning at anytime.This is a Panaga School Community event only. Please wear cultural attire (whatever that may mean for you) and send children to school with a country flag (or flags) if possible to wave in the parade.

School arrival
● 7.40am P1 to arrive atTeraja
● Pre Nursery and Nursery children to be with parents if attending. PN and N classrooms will open at 8.30am.
● P2 and P3 dropped to Rampayoh at usual time and will walk across toTeraja.
● P4-M2 to class for the start of day as usual
7.50am
Classes assemble around the perimeter ofTeraja, parading a lap, finishing under the Teraja tent where they will sing together.
8-8.30am
● Pre Nursery and Nursery with supervising parent/carer to look at stalls. Pre Nursery and Nursery classes open from 8.30am.
● P1 and P2 - will be supervised by teachers
● P3 with P4 - together in class
● P5 - P7 back to classes
8.30am - 9.15am P1 and P2 tour stalls
9.15am - 10.15am P3 and P4 tour stalls
10am - 11am P5 and P6 tour stalls
10.30am - 11.30am P7 to M2 tour stalls
More information and reminders will be sent to parents ahead of the event.
Please contact organisers: Marie or Kamila if needed maree.tupper@hotmail.com or k.rosa.celik@gmail.com





































































































Teraja and Melilas had an action packed first week back to Term 2 undertaking science week. There were workshops, music, dances, trips and a crime to be solved. They worked together to use and develop a wide range of science knowledge and skills and making links across the curriculum.


























All students had a fantastic time at the Seria Energy Lab. We undertook 3 different activities:





-guided tour of the exhibition hall -Science wizardry theatre show -chance to explore the exhibition in groups with teachers







There was a wealth of interactive and informative displays covering wide range of scientific concepts that complement the work we do in all year groups.

































It’s not magic….. it’s Science!



















This week the children have set up their own investigations to find out if dark chocolate melts at the same rate as white chocolate.They timed how long it took for each type of chocolate to melt.







P5 helped investigate the mystery of the missing house cup. They used chromatography to investigate which of the suspects pens was used to write the note left in the laboratory.





P5 have been learning about fitness and collaboratively designed an outdoor gym. Children looked at the benefits and effects of exercise on the body and mind.




There’s a hole in my bucket
P5 tried to solve an age-old problem: what material is the best to cover a hole in a bucket so it does not leak? The children tested a range of materials to decide which was the most suitable.












Newton’s First Law of Motion was a topic of discussion when we worked together to design an outdoor fairground game. Every game that was designed was creative, fun, engaging and different. Wonderful learning and great teamwork.



● How much force is needed to knock over our pins?
● Does a larger ball mean that it has more power?









I learnt that you have to make the weight of the bottle heavy in order to tip over. I enjoyed learning with new people too -Aarohi





We learnt that mud and rock is too heavy - Harris
I enjoyed that we got to play each others’game - Mariano


















the investi ation o the missin house points trophy. The children analysed soil samples rom the scene o the crime to determine i they were acid or alkaline, usin litmus paper.








P5 worked in the Science Lab to analyse a ran e o fibers that were ound at the crime scene! Children used microscopes, observation and enquiry skills to match the suspects with items that were ound at the crime scene!





















The P6 orensic team worked like orensic scientists this week, testin various blood samples in the lab to cate orise suspects in the Science Week Pana a crime scene. The students ollowed correct procedures and methods to find out which sample would coa ulate usin specified chemicals. The students displayed reat cooperation, teamwork and communication skills in the process.

It was really fun and Really enjoyed it! I wondered who stole the cup! I loved all the tricky bits on testing the blood in the lab. We had to be resilient and used the cooperation and enquiry in the lab! -Madeline

It was super fun and cool. We had to use some substances, fake blood and identify whose blood is it - Gregory
I thought it was fun! I used resilience and I loved doing the blood test! -Jake





We looked at magnetic and levitation.
We talked about the things magnets could do, for example there was a development with magnets that could hold extremely hot states of matter - As hot as the sun!











On the 12th o January, P7-M2 went to three activities, two o which were Dancin and Music.
Durin music, we learned about how sound travels in waves and how you can chan e those waves or add effects to them to make them sound different. Then we went onto soundtrap with a partner or by ourselves and experimented with modulated and au mented sounds.
Durin dance, we used the son bounce, to choreo raph our own al orithm dances. We used a variety o moves to represent the music type. Once we made the dance we desi ned our own symbols to match up with it.








You’veheardofPoetryWeek,you’veheardofMathsWeek…nowgetreadyforScience Week. A jam-packed, STEAM-filled five days, stocked with workshops, a school trip, and presentations. My fellow students and I got the opportunity to attend workshops on topics such as Ergonomics, Nanotechnology, and Electricity, and to develop our own ideas of what the future of technology looks like. Pupils and teachers alike got the privilege to see presentations for creations dreamed up by us students, ranging from P7 to M2. The ideas and execution were extraordinary; innovations such as the Smart Table, Virtual Reality Schools for long-distance or at-home learning, and a substance thatcouldmakeallyourclothesanddevicesliquid-proofweresharedwiththeschool.


An incredible trip to the Seria Energy Lab enlightened students on subjects related to Shell: different types of crude oil, how to extract it, information about nodding donkeys and other equipment used for extraction. Alongside the traditional visual and audible learning,thereweremanykinestheticactivitiesavailableaswell-ahelicoptersimulator, an aquarium (one of the largest in Borneo,) and a game powered by cycling, to name a few. The excursion also included a magic show, demonstrating how things that seem to beimpossiblearemadepossiblebyusingScienceandlogic.I’msurethatmanystudents wouldrecommendavisittotheSeriaEnergyLab;IknowthatIwould!
We spent a day circulating around school, finding out different ways that we can incorporate Science into our daily lives. Discovering how we can choreograph a dance routine using algorithms, distorting music and audio using a digital software named Soundtrap, and making a poster on what we’ve learnt, understood, and become able to do this week. Each session lasted two hours, separated by break, lunch, and the start and endofschool,andeachonedemonstratedjusthowinterestingSciencecanbe.
Science Week has been an amazingly well constructed few days, full to the brim with fascinating lessons and workshops, awesome opportunities to take part in, and memorable experiences. Thank you to Mr. Stephen and all of the teachers involved for planning and carrying out this spectacular week; your efforts and help are noticed and appreciateddeeply.






Dear Parents,
Term 2’s Scholastic Book Club is up and running and you can now browse the latest books and order online.There are hundreds of fantastic Children’s books to choose from, all at great prices!

For every purchase in this term’s Book Club, our school will earn 20% of the value in rewards to buy books for our library.
Go to https://world-schools.scholastic.co.uk/panaga-school-kb3534/digital-book-club

Please place your order directly online by January 31st, 2023.
Click on either AGES 0-6, 7-11 or 11+ or you can use the search box for specific titles that you are interested in.
Please add the books that you would like to order into your basket
Once you have finished and are happy with your order, please click on your basket in the top right hand corner of the screen to proceed to the checkout.
You will then need to enter your email address and choose a password
Once you have done this, you can enter the payment details for your order and checkout. If you have any questions regarding placing your order at any time you can email intschool@scholastic.co.uk or call +44 1993 893474
Or email the school contact, Miss Shelagh shelaghgreen@panagaschool.com
Kind regards, Miss Shelagh
